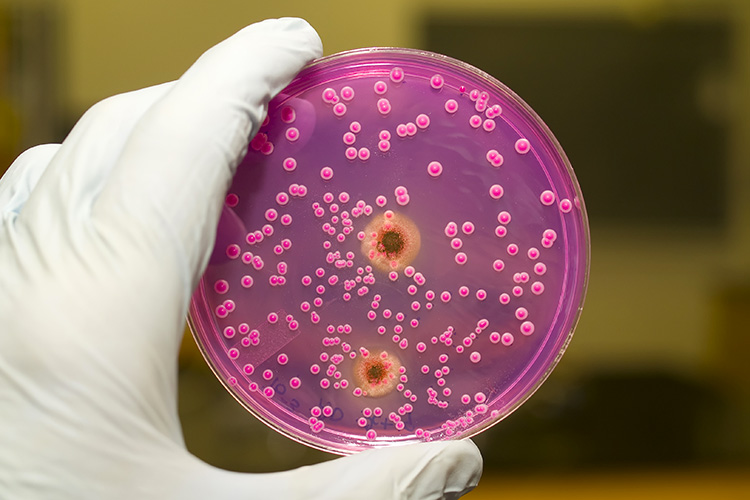

È il sistema di sanificazione rivolto alle aree ad alta frequentazione (come aeroporti, stazioni, centri commerciali, uffici pubblici, scuole, laboratori medici, palestre e spa, ecc.).
Sanificazione ambientale certificata
Sappiamo bene come la formazione di microrganismi patogeni nelle condotte idriche e aerauliche sia inevitabile, per questo, nell’ambito delle pulizie generali ci occupiamo anche della prevenzione del rischio biologico.
Le procedure metodologiche di sanificazione certificata sono compiute da un settore specifico dell’azienda che si occupa esclusivamente di problematiche ambientali legate al benessere dell’habitat lavorativo (monitoraggio e analisi dei livelli batteriologici dell’aria e dell’acqua) e domestico.
Le procedure metodologiche di sanificazione certificata sono compiute da un settore specifico dell’azienda che si occupa esclusivamente di problematiche ambientali legate al benessere dell’habitat lavorativo (monitoraggio e analisi dei livelli batteriologici dell’aria e dell’acqua) e domestico.
Le nostre procedure seguono le ultime linee-guida nazionali (7/5/2015) e regionali legate alla valutazione del rischio biologico e sono effettuate da un team di biologi:
- ispezione e campionamenti;
- analisi microbiologiche presso laboratori accreditati;
- (nel caso di contaminazione) entro 24 ore dall’ avvio della procedura di decontaminazione utilizzando i trattamenti necessari a seconda di ciascun caso;
- nuova ispezione e relativi campionamenti per la verifica dell’efficacia dei trattamenti.
Grazie a questo corretto sistema garantiremo una certificazione seria e di qualità, da allegare alla documentazione della valutazione di rischio dell’azienda ed esibire in occasione delle verifiche degli organi di controllo.